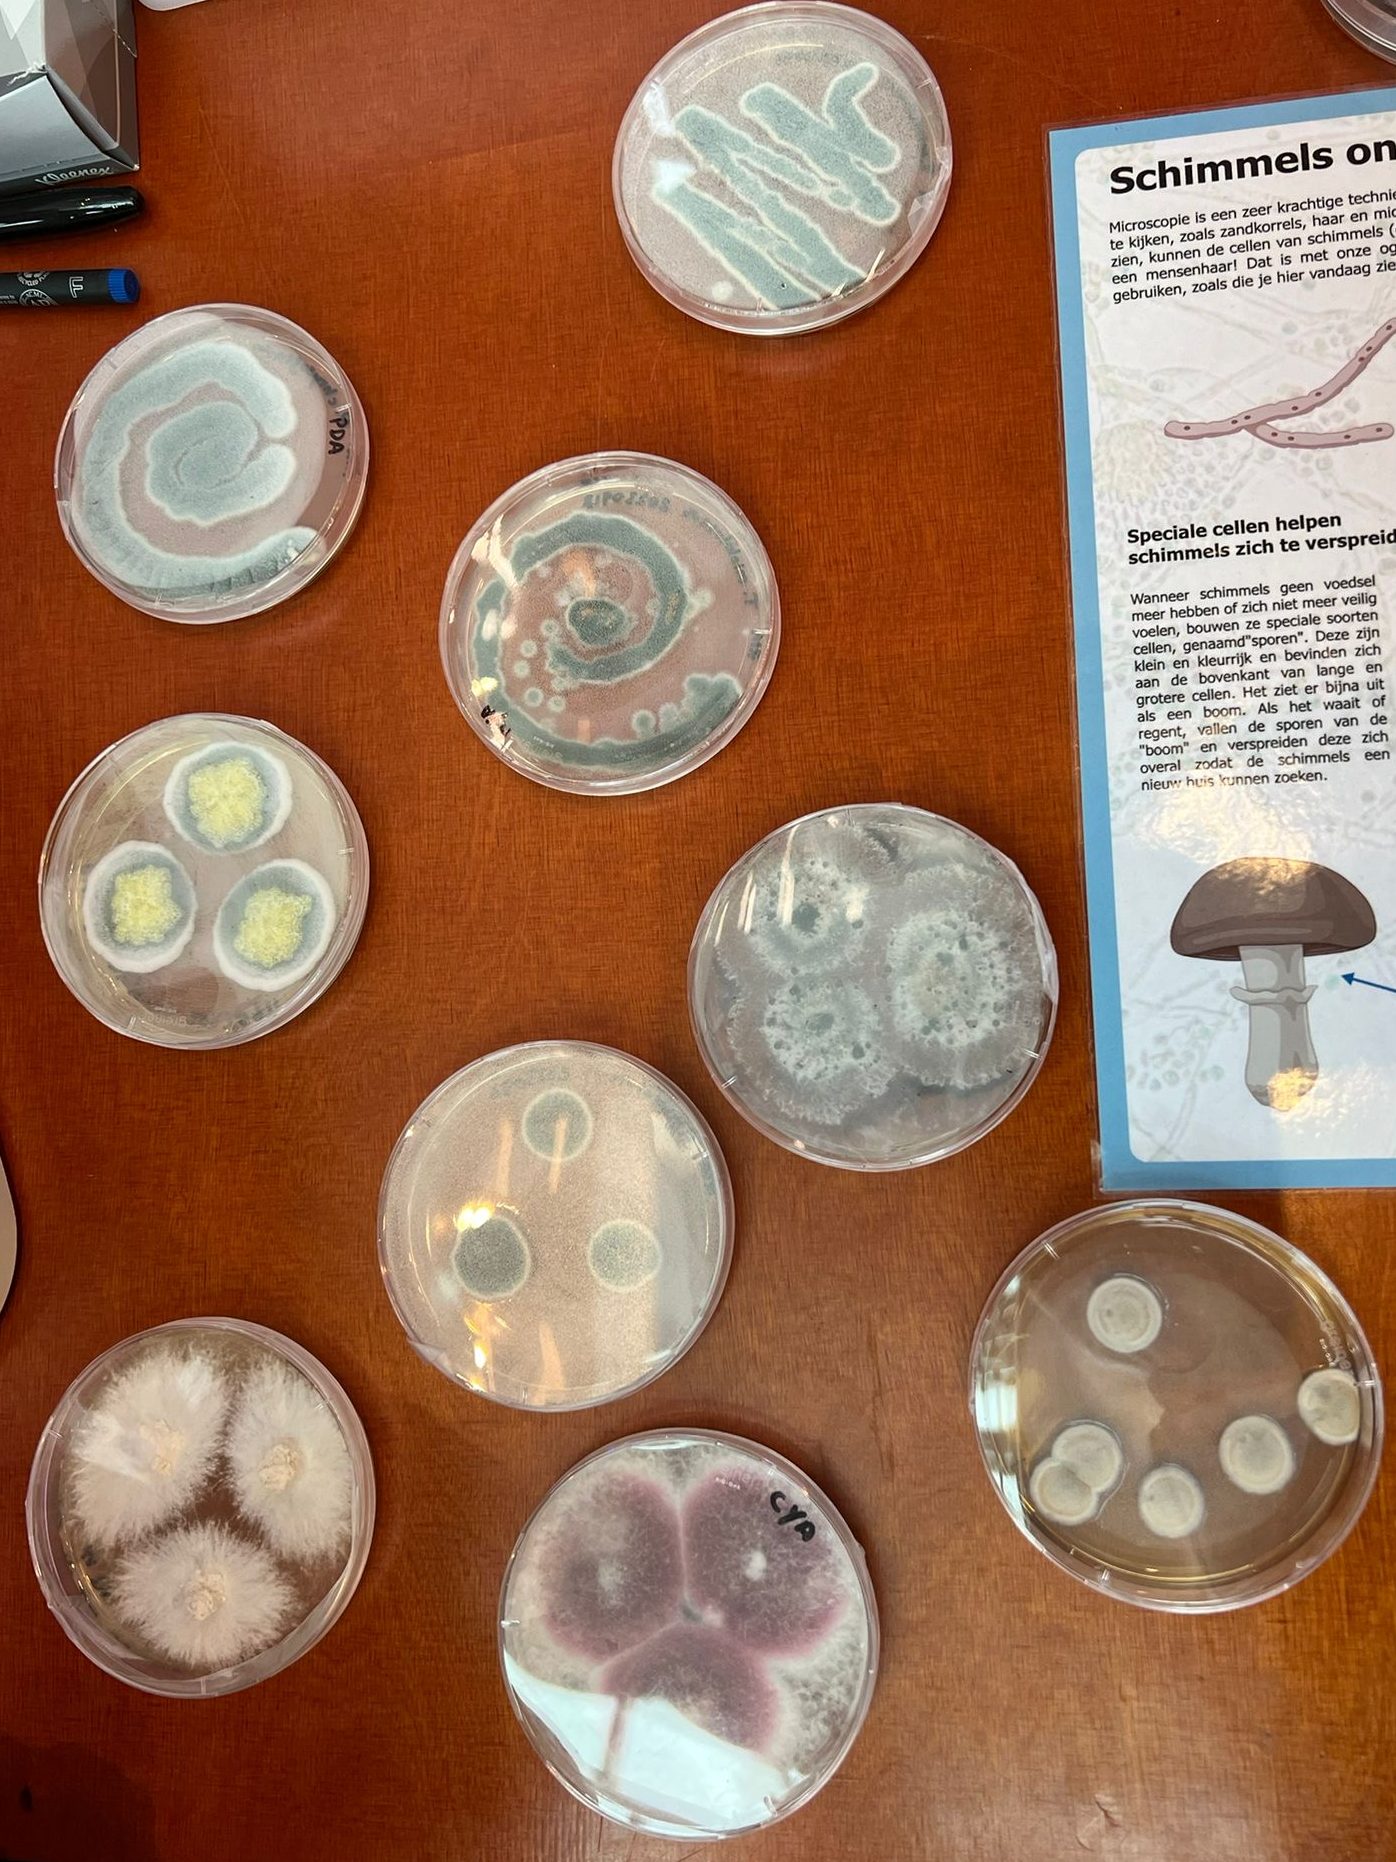

Playdoh mushrooms made by children at our ‘Fun with Fungi’ exhibit.
This activity was inspired by the science outreach activities of the British Society of Mycology (https://www.britmycolsoc.org.uk/)
September 30, 2023:





















































October 1, 2022:







































































Playdoh mushrooms made by children at our ‘Fun with Fungi’ exhibit.
This activity was inspired by the science outreach activities of the British Society of Mycology (https://www.britmycolsoc.org.uk/)
September 30, 2023:

October 1, 2022:






































































